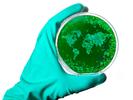

NPR/TED Staff appears in the following:
Susan Pinker: What Makes Social Connection So Vital To Our Well-Being?
Friday, April 24, 2020
Psychologist Susan Pinker explains why face-to-face connection is a human necessity. But during this period of isolation, she says some ways of connecting online are better substitutes than others.
Jonny Sun: You're Not Alone In Feeling Lonely
Friday, April 24, 2020
For Jonny Sun, loneliness felt like being an alien on a distant planet, alone in the universe. But when he shared those feelings online, he found a community of people who felt precisely the same way.
Postcards From The Pandemic: Pico Iyer
Friday, April 17, 2020
Over the past weeks, we've been reaching out to TED speakers to ask how their lives have changed since COVID-19. On this episode, we hear from writer Pico Iyer, at his home in Nara, Japan.
Helen Walters: Ideas That Bring Us Joy
Friday, April 17, 2020
More than ever, we need to make time for joy. This hour, Manoush and TED's Head Curator Helen Walters explore talks that surprise, inspire, and delight.
Postcards From The Pandemic
Friday, April 10, 2020
Over the past weeks, most us have had to adapt to a new normal. We reached out to a few TED speakers to ask how their lives have changed and what they're thinking about these days.
Daniel Streicker: What If We Could Stop A Virus At Its Animal Source?
Friday, April 10, 2020
MERS, Ebola, and COVID-19—the viruses that cause these diseases likely have the same patient zero: bats. For researcher Daniel Streicker, the key to preventing an outbreak is the bats themselves.
Anupam Jena: What Are Some Less Obvious Ways COVID-19 Could Change Our Lives?
Friday, April 10, 2020
Anupam Jena has made a practice of looking at big data and natural experiments to ask questions others overlook. He describes how the COVID-19 pandemic could have several unexpected consequences.
Laura Spinney: What Does The 1918 Flu Teach Us About Our Response To Pandemics?
Friday, April 10, 2020
A century after the 1918 flu, we see similar patterns in the ways we're responding to COVID-19. Laura Spinney reflects on the Spanish flu and how societies learn to move forward after pandemics.
Heidi Larson: Why Is Trust In Vaccines Just As Important As Vaccines Themselves?
Friday, April 10, 2020
In 2003, polio reemerged in twenty countries that had long been declared polio-free. Anthropologist Heidi Larson says to stop the spread of disease, we need to first build trust in vaccines.
Jacqueline Woodson: What Is The Hidden Power Of Slow Reading?
Friday, April 03, 2020
Novelist Jacqueline Woodson is a slow reader. Taking her time lets her savor each word brings her closer to each story, and it lets her pay respect to her ancestors who weren't allowed to read.
Liz Kleinrock: How Can We Broach Hard Conversations With Kids, From Race To COVID-19?
Friday, April 03, 2020
When one of Liz Kleinrock's fourth grade students made a cringeworthy comment about race, rather than change the subject, she chose to turn the moment into a teachable one—and start a conversation.
Thomas Curran: How Can We Teach Kids To Accept Imperfection?
Friday, April 03, 2020
Many students feel unrelenting pressure to be... perfect. Social psychologist Thomas Curran warns that striving for perfectionism isn't just impossible—it's also dangerous to children's health.
Richard Culatta: Can This Crisis Revolutionize The Way We Teach?
Friday, April 03, 2020
What does a global pandemic mean for our education system? Educator Richard Culatta discusses the ways we can teach for better humans virtually... and the opportunity this moment presents.
Margrethe Vestager: How Can We Ensure Fair Competition Online?
Friday, March 20, 2020
When we shop in a store, we're used to having options. But in a digital economy controlled by tech monopolies, choice isn't built in. Margrethe Vestager is on a mission to change that.
Claire Wardle: Why Do We Fall For Misinformation?
Friday, March 20, 2020
How does a set of misleading videos online turn into a dangerous health crisis ... all in the span of three days? Claire Wardle discusses the real life consequences of misinformation online.
Zeynep Tufekci: How Do We Build Systems Of Trust Online?
Friday, March 20, 2020
With so much data collected on our online behavior, it's bound to be misused. Sociologist Zeynep Tufekci says to rebuild trust in the internet, we need to entirely restructure how it operates.
Adam Alter: How Do We Take Back Control Of Our Attention?
Friday, March 20, 2020
Within the last decade, we've opted to replace time spent on hobbies, exercise, and conversation with screen time. Social psychologist Adam Alter describes ways we can reclaim our attention.
Edward Snowden: Why Does Online Privacy Matter?
Friday, March 20, 2020
Edward Snowden revealed government programs that collected our private data. Today, he says private corporations have become just as intrusive—but without the restraints placed on government.
Nick Hanauer: How Do We Begin To Reinvent Capitalism?
Friday, March 13, 2020
Billionaire entrepreneur Nick Hanauer says that today's inequality results from decades of bad economic theory. He argues for a reinvention of our capitalist system and our definition of prosperity.
Michael Tubbs: What Does It Take To Transform A Struggling City?
Friday, March 13, 2020
Michael Tubbs has been saying "reinvent Stockton" since he was elected. Having grown up in Stockton himself, Tubbs takes a community-oriented approach to creating positive change in the city.